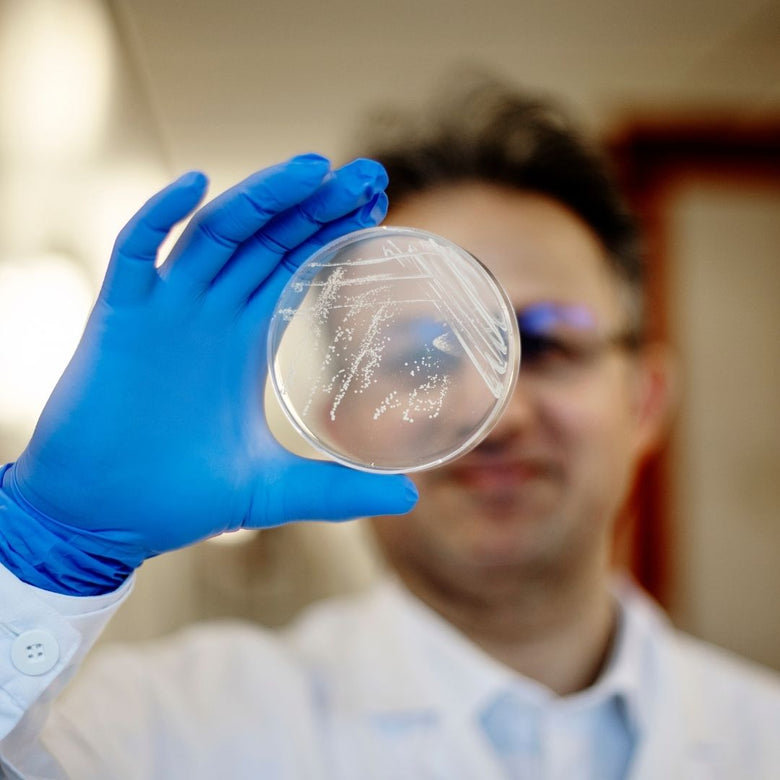
Dr. Lavasani examines a petri dish with probiotic bacteria– over 20 years of research.

- Article published at:
- Article author: Shahram Lavasani
- Article tag: food sensitivity
- Article comments count: 0
Drawer menu
Based on over 20 years of probiotic research
GutMagnific is a unique science-based and patented multi-strain probiotic supplement. It is the result of more than 20 years of groundbreaking research and deep understanding of the complex interplay between the microbiome, immune system, and intestinal barrier.
Five unique strains of lactobacillus
GutMagnific® contains 5 unique, safe, and naturally occurring Lactobacillus strains, originally sourced from traditionally healthy food. Developed by pharmaceutical quality standards, these strains are combined in a multi-strain blend designed to work on multiple levels within the gut environment.
Patented formulation
GutMagnific® features a patented combination of probiotic strains available exclusively in this product. The formulation is the result of over two decades of dedicated development and is supported by clinical research collaborations.
Customer-recommended
GutMagnific® continues to receive strong, positive feedback from users. Many customers choose to return and recommend the product to others—reflected in consistently high ratings and a 96% recommendation rate.
Based on over 20 years of probiotic research
GutMagnific is a unique science-based and patented multi-strain probiotic supplement. It is the result of more than 20 years of groundbreaking research and deep understanding of the complex interplay between the microbiome, immune system, and intestinal barrier.
Five unique strains of lactobacillus
GutMagnific® contains 5 unique, safe, and naturally occurring Lactobacillus strains, originally sourced from traditionally healthy food. Developed by pharmaceutical quality standards, these strains are combined in a multi-strain blend designed to work on multiple levels within the gut environment.

Patented formulation
GutMagnific® features a patented combination of probiotic strains available exclusively in this product. The formulation is the result of over two decades of dedicated development and is supported by clinical research collaborations.

Customer-recommended
GutMagnific® continues to receive strong, positive feedback from users. Many customers choose to return and recommend the product to others—reflected in consistently high ratings and a 96% recommendation rate.


A new category of multi-strain formulations, developed using scientific methods to reflect the complex interplay between the gut microbiota, the immune system, and the intestinal barrier.

A unique combination of five strains, exclusively found in the GutMagnific® product line, all originating from healthy foods.

GutMagnific® is developed through a research-based process, in close collaboration with healthcare professionals, researchers, and with a strong focus on users’ needs.
At ImmuneBiotech, we develop cutting-edge probiotics grounded in the latest scientific research and supported by clinical collaborations. Our work is built on close partnerships with patients, healthcare professionals, researchers, and leading clinics, including Lund University Hospital and the Karolinska Institute in Stockholm.
Not all probiotics are developed in the same way. To ensure the highest scientific standards, probiotic development should follow a targeted, research-driven approach, designed to meet specific needs. We believe that an effective probiotic formulation should be carefully designed to act on multiple levels, offering a comprehensive approach to support gut-related functions.
With more than 20 years of dedicated research, the ImmuneBiotech team has introduced a new category of probiotics—ImmuneBiotics. GutMagnific®, the first product in this category, is carefully formulated to support the gut environment on several fronts, including balancing the microbiota, supporting immune interactions, and maintaining gut barrier integrity.






